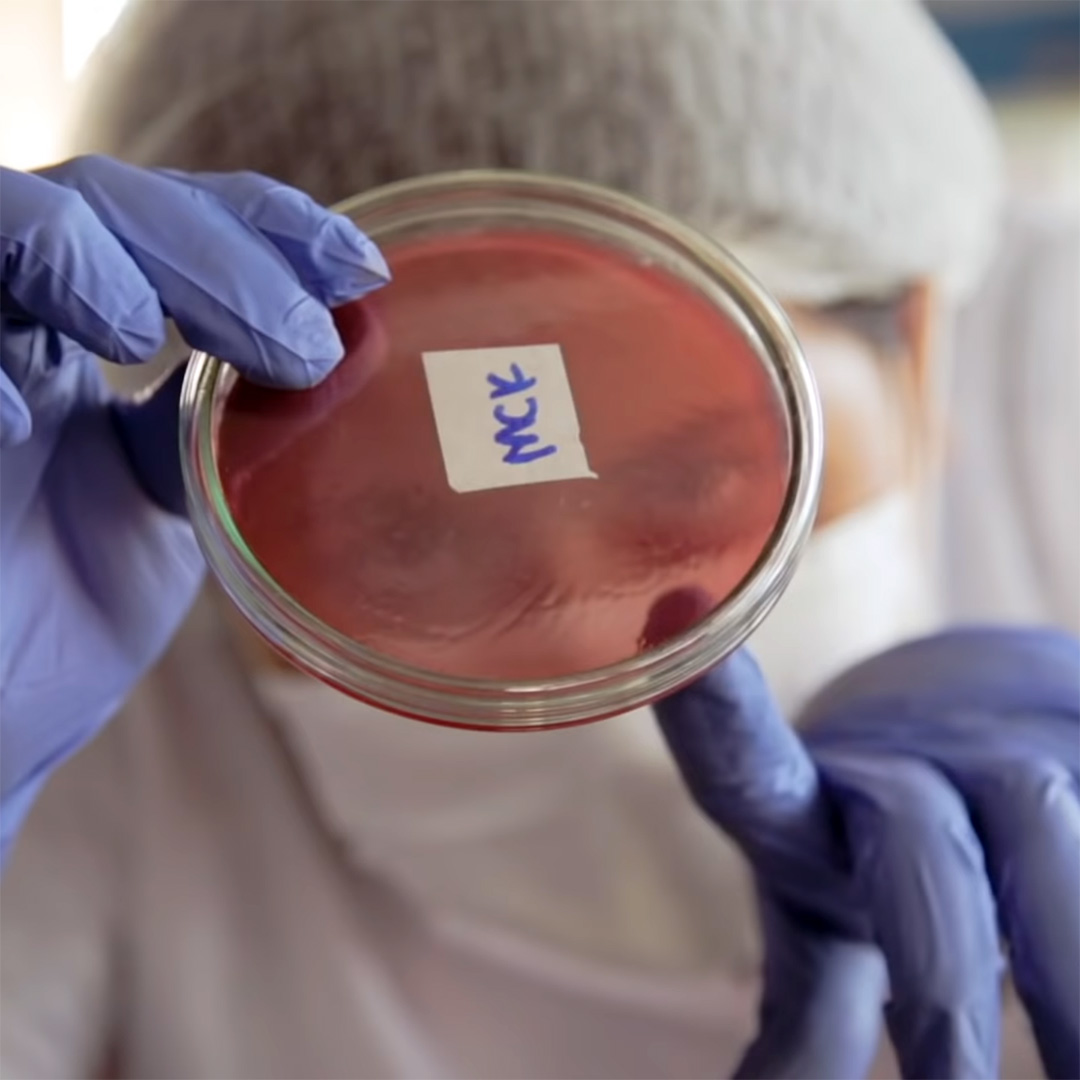

Es momento de aprender a través a la televisión pública para qué sirve la ciencia. El Ministerio de Ciencia, Tecnología e Innovación (MinCiencias) trae a la pantalla de Señal Colombia la serie documental Fórmulas de cambio, una producción que cuenta historias de vida que han sido transformadas por el conocimient científico.
En un recorrido por diferentes regiones de Colombia, Fórmulas de cambio presenta personajes que han transformado sus comunidades a través del ejercicio científico e investigativo, el cual los llevó a cambiar su destino y el de los demás integrantes de su comunidad. Esta serie es una breve radiografía de lo que está sucediendo con las mentes innovadoras que cambiarán el futuro del país con sus aportes.

Para mostrarnos los beneficios de aplicar la ciencia en la vida cotidiana, la producción hace uso de entrevistas, puestas en escena y descripciones visuales del contexto geográfico con los que se narran los casos de colombianos emprendedores con historias inspiradoras que se han dedicado a trabajar para mejorar sus entornos y el de toda la comunidad.
En otras palabras, esta serie documental es una apuesta para visibilizar a quienes se animan a usar sus conocimientos y ponerlos en práctica para ser agentes de cambio y aportar así a la inclusión, el desarrollo social y la paz desde el campo científico.
Fórmulas de cambio es además una de las acciones contempladas dentro de la estrategia Difusión de la ciencia, la tecnología y la innovación, uno de los esfuerzos que hace la Dirección de Mentalidad y Cultura de Colciencias, con el propósito de generar y fortalecer una cultura que valore y gestione la apropiación social del conocimiento con experiencias que contribuyan a mejorar la percepción que tienen los colombianos sobre temas científicos.
No te pierdas esta serie documental nominada dos veces en los Premios India Catalina, en la categoría Mejor Nuevo Creador.



